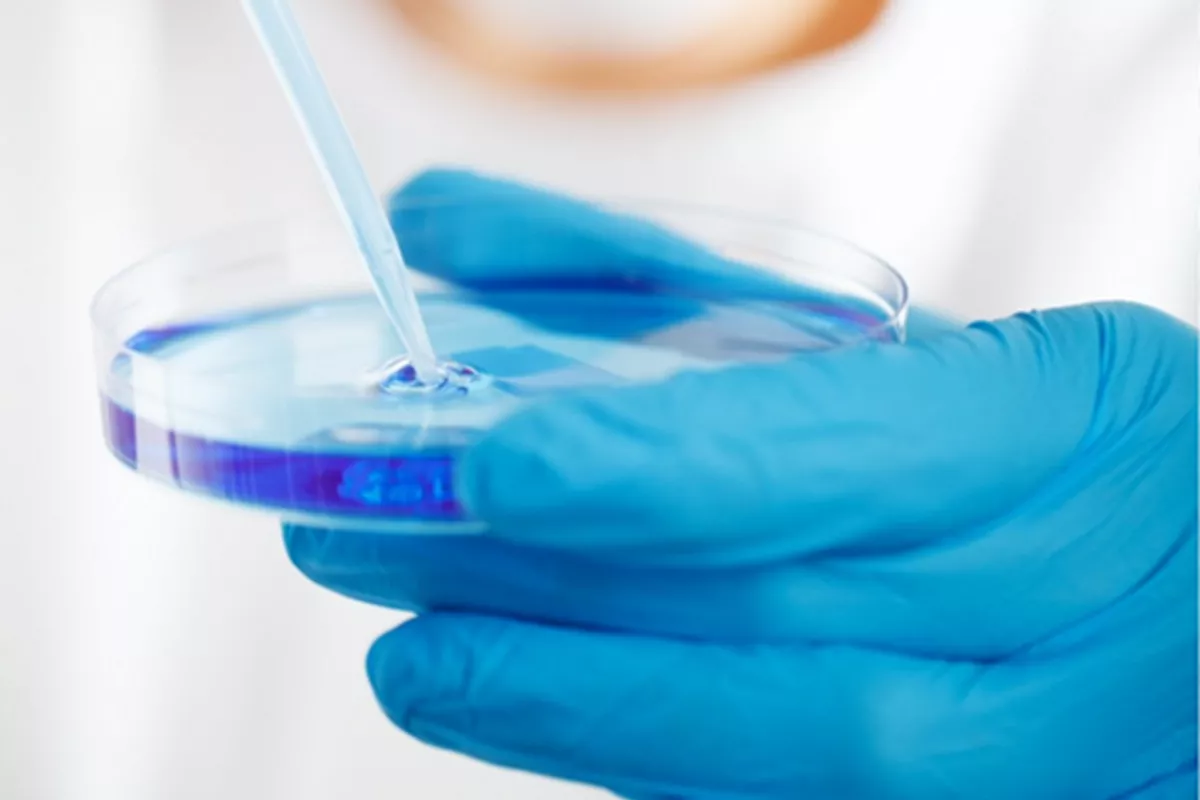

Данные о наличии в продукте патогенных бактерий были опубликованы в «Едином реестре проверок» Генпрокуратуры РФ.
Информация о том, что в продукте, выпускаемом под брендом «Коровка из Кореновки», обнаружены патогенные микроорганизмы, в том числе сальмонеллы, была опубликована в «Едином реестре проверок» Генпрокуратуры РФ. Ее «Кубанским новостям» прокомментировали в пресс-службе компании «Ренна»( «Коровка из Кореновки», «Алексеевское» и др.).
- Заключение о присутствии сальмонеллы в продукции «Коровка из Кореновки» выдано частной лабораторией, а речь идет о продукте, срок годности которого на данный момент давно истек. Следовательно, никак подтвердить или опровергнуть информацию нельзя. Проверка начата именно на основании обращения по этому протоколу. Отметим, также, что в конце марта была проведена проверка Роспотребнадзора с проведением порядка 150 анализов оборудования и готовой продукции, включая сметану, о которой идет речь. Никаких нарушений также не выявлено, - говорится в официальном сообщении. - Подтверждений факта, о котором идет речь в материалах частной лаборатории, со стороны официальных государственных органов нет. Мы находимся в тесном контакте с коллегами из надзорных ведомств, разбираемся в наличии оснований для данного обвинения.